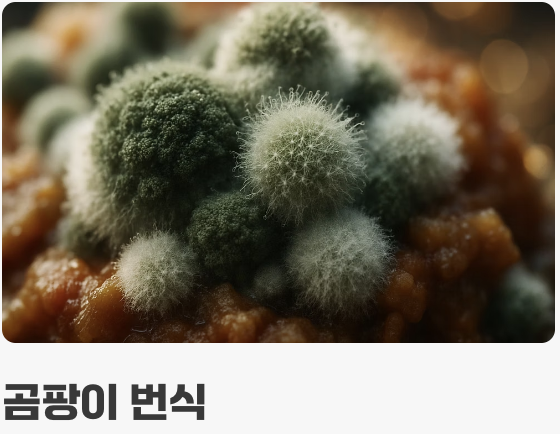
눈에 보이지 않는 진짜 위험

쌀을 씻으려는데 물 위로 둥둥 떠오르는 까만 점들, 혹은 쌀통 구석에 거미줄처럼 엉겨 붙은 쌀알들을 보고 가슴이 철렁 내려앉은 경험, 있으신가요? 아까운 쌀을 버려야 하나, 아니면 옛 어르신들 말씀처럼 벌레만 골라내고 먹어도 괜찮을까 하는 깊은 고민에 빠져 이 글을 찾아오셨을 겁니다.
이 오래된 질문에 대한 결론부터 말씀드리겠습니다. 쌀벌레 자체에 맹독이 있는 것은 아니지만, 위생과 건강을 생각한다면 절대 권장하지 않습니다. 눈에 보이는 벌레 몇 마리가 문제가 아니라, 그들이 남겨놓은 보이지 않는 오염 물질이 진짜 위험이기 때문입니다. 이 찝찝한 상황을 명쾌하게 해결하는 유일한 길은, 오염된 곡물을 과감히 처리하고 올바른 보관법을 통해 재발을 막는 것입니다.
쌀통 속 불청객의 정체


우리가 ‘쌀벌레’라고 부르는 것들은 보통 두 종류입니다. 딱딱한 껍질을 가진 까만 ‘쌀바구미’와, 나방의 애벌레 형태인 하얀 ‘화랑곡나방 유충’이죠. 이들은 쌀의 영양분을 먹고 자라며 그 안에서 알을 낳고, 번데기가 되고, 어른벌레가 되는 생의 모든 과정을 반복합니다.
즉, 우리가 발견한 몇 마리의 성충은 거대한 빙산의 일각일 뿐입니다. 이미 쌀알 깊숙한 곳에는 우리 눈에 보이지 않는 수많은 알과 유충, 그리고 그들의 배설물과 탈피 껍질이 뒤섞여 있을 가능성이 매우 높습니다. 문제는 단순히 쌀의 영양가가 떨어지는 것에서 그치지 않습니다.
골라내고 먹어도 정말 괜찮을까?


“벌레만 잘 씻어내면 단백질 보충도 되고 괜찮다”는 우스갯소리도 있지만, 이는 현대 위생 관점에서는 매우 위험한 생각입니다. 쌀벌레가 먹고 배설하는 과정에서 쌀은 단순한 ‘벌레 먹은 쌀’이 아니라 ‘오염된 쌀’로 변질되기 때문입니다.
우리가 물로 씻어낼 수 있는 것은 성충이나 일부 유충, 그리고 가벼운 가루들뿐입니다. 쌀알 속에 파고들어 알을 낳는 쌀바구미의 경우, 쌀알을 쪼개지 않는 이상 내부의 알까지 제거하는 것은 불가능합니다. 또한, 이들이 남긴 배설물과 분비물은 밥을 지어도 그대로 남아 우리 몸속으로 들어오게 됩니다.
눈에 보이지 않는 진짜 위험

쌀벌레가 생긴 쌀을 먹었을 때 가장 우려해야 할 점은 바로 ‘2차적인 곰팡이 오염’입니다. 벌레들이 쌀알에 상처를 내고, 그들의 활동으로 인해 쌀통 내부의 온도와 습도가 올라가면 곰팡이가 번식하기에 최적의 환경이 조성됩니다.
일부 곰팡이는 아플라톡신과 같은 매우 위험한 1급 발암물질인 ‘곰팡이 독소’를 만들어 낼 수 있습니다. 이 독소는 열에 매우 강해 밥을 짓는 과정에서도 파괴되지 않으며, 장기간 섭취 시 간에 치명적인 손상을 줄 수 있습니다. 눈에 보이는 벌레보다, 보이지 않는 곰팡이 독소가 훨씬 더 무서운 이유입니다.
아까운 쌀, 어떻게 해야 할까?


그렇다면 이미 벌레가 생긴 쌀은 어떻게 처리해야 할까요? 가장 안전하고 확실한 해결책은 양이 아무리 많고 아깝더라도, 음식물 쓰레기가 아닌 일반 쓰레기로 밀봉하여 ‘과감하게 폐기’하는 것입니다. 당신과 가족의 건강이 아까운 쌀 몇 킬로그램보다 훨씬 더 소중하기 때문입니다.
만약 벌레가 생긴 지 얼마 되지 않아 그 수가 매우 적고 오염이 심하지 않다고 판단된다면, 햇볕이 좋은 날 넓게 펴서 말려 벌레를 기어 나오게 하거나, 냉동실에 며칠 얼려 벌레를 죽인 뒤 수십 번 이상 깨끗하게 씻어 사용하는 방법도 있습니다. 하지만 이는 어디까지나 차선책이며, 밥보다는 떡이나 죽처럼 오래 가열하는 다른 용도로 활용하는 것이 그나마 안전합니다.
최고의 해결책은 ‘예방’입니다


이 모든 불쾌한 고민을 하지 않는 가장 완벽한 방법은 애초에 쌀벌레가 생기지 않도록 철저하게 예방하는 것입니다. 몇 가지 간단한 습관만으로도 우리 집 쌀통을 안전하게 지킬 수 있습니다.
가장 효과적인 방법은 쌀을 구매한 즉시, 원래 포장지에서 꺼내 페트병이나 밀폐 용기에 소분하여 냉장 보관하는 것입니다. 낮은 온도는 벌레의 알이 부화하는 것을 원천적으로 막아줍니다. 냉장고 공간이 부족하다면, 껍질을 깐 통마늘이나 붉은 고추, 혹은 숯을 쌀통에 함께 넣어두는 것도 벌레의 접근을 막는 데 도움이 됩니다. 또한, 너무 많은 양의 쌀을 한 번에 구매하기보다는, 조금씩 자주 구매하여 빨리 소비하는 습관을 들이는 것이 현명합니다.
자주 묻는 질문 (FAQ)


Q. 쌀벌레는 묵은쌀에서 저절로 생기는 건가요?
A. 아닙니다. 쌀벌레는 저절로 생기지 않습니다. 대부분 쌀을 수확하거나 도정하는 과정에서 이미 쌀알에 묻어있던 알이, 집안의 따뜻한 온도(25도 이상)에서 부화하여 번식하는 것입니다.
Q. 실수로 쌀벌레가 들어간 밥을 조금 먹었는데, 괜찮을까요?
A. 건강한 성인이라면 소량 섭취했다고 해서 즉각적으로 심각한 문제가 생길 가능성은 낮습니다. 하지만 찝찝한 것은 사실이며, 복통이나 설사, 알레르기 반응 등이 나타난다면 병원을 방문하는 것이 좋습니다.
Q. 쌀 말고 다른 잡곡에도 벌레가 생기나요?
A. 네, 그렇습니다. 쌀벌레(화랑곡나방, 쌀바구미)는 쌀뿐만 아니라 현미, 보리, 콩, 밀가루, 시리얼, 견과류 등 거의 모든 건조 곡물을 좋아합니다. 모든 잡곡은 쌀과 마찬가지로 밀폐하여 서늘한 곳이나 냉장고에 보관하는 것이 가장 안전합니다.
쌀벌레 완벽 종합 가이드 – 발생 원인, 퇴치법, 예방까지 한눈에
쌀벌레 완벽 종합 가이드 – 발생 원인, 퇴치법, 예방까지 한눈에
따끈한 밥을 짓기 위해 쌀통을 열었는데, 그 안에서 까만 벌레들이 기어 다니는 것을 발견하고 소스라치게 놀란 경험, 있으신가요? 애써 사 온 귀한 쌀을 전부 버려야 하나 막막하고, 우리 집 위
ths.sstory.kr
추가 정보 및 도움이 되는 자료
- 쌀벌레 생긴 쌀 사용하는 법 (쌀벌레 없애는 법, 예방법) - 미르사전
쌀벌레 생긴 쌀은 깨끗이 씻어 먹으면 무방하지만 찝찝하면 버려도 된다. - [스마트 리빙] 벌레 생긴 쌀, 그냥 먹어도 될까? - MBC
벌레 먹은 쌀은 물에 뜨면 버리고 일반적으로는 잘 씻어 먹어도 된다. - 쌀벌레 생긴 쌀, 밥해 먹어도 될까? - 다음뉴스
쌀벌레 생긴 쌀은 깨끗이 여러 번 씻으면 먹을 수 있지만, 오래된 쌀은 버리길 권장한다. - 쌀벌레 - 나무위키
쌀벌레 있는 쌀도 잘 씻으면 먹어도 되지만 식감과 영양 가치가 떨어진다.